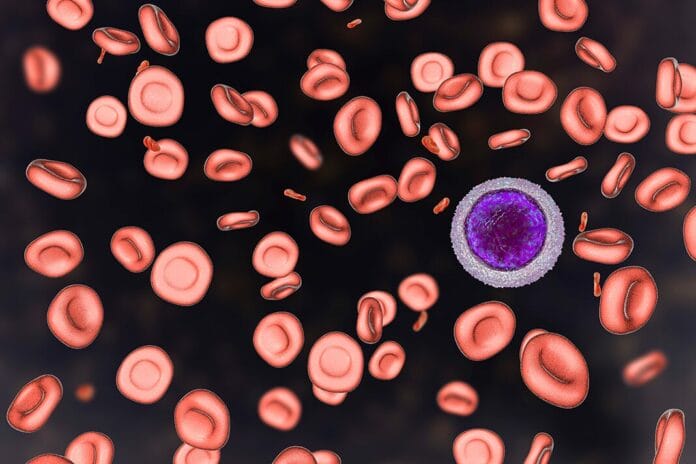
A Hygienist’s Overview of the Effects of Iron-Deficient Anemia on Oral Health

Spring Hatfield, RDH, BSPH
Hand Hygiene: How Effective Are Alcohol-Based Hand Sanitizers against Non-Enveloped Viruses?
The very first thing I learned clinically in dental hygiene school was hand hygiene. Proper handwashing was the first, and admittedly the most stressful,...
Curiosity Killed the Plaque Ep. 38: Differentiating between Robust Evidence and Misinformation
In this episode of Curiosity Killed the Plaque, Spring Hatfield, RDH, BSPH, examines misinformation and how to distinguish it from robust evidence.
Give it a...
Curiosity Killed the Plaque Ep. 37: Cephalic and Dental Origin Tetanus
In this episode of Curiosity Killed the Plaque, Spring Hatfield, RDH, BSPH, takes a look at cephalic and dental origin tetanus.
Give it a watch,...
An Evaluation of the FDA’s Proposed Removal of Fluoride Prescription Drugs from the Market
Pediatricians and dental professionals have utilized prescription fluoride tablets and drops for decades. Yet, the U.S. Food and Drug Administration (FDA) has proposed to...
Curiosity Killed the Plaque Ep. 36: Fentanyl Exposure, Overdose Signs, and Management
In this episode of Curiosity Killed the Plaque, Spring Hatfield, RDH, BSPH, examines fentanyl exposure in a dental setting.
Give it a watch, and make...
Curiosity Killed the Plaque Ep. 35: Skull Evolution
In this episode of Curiosity Killed the Plaque, Spring Hatfield, RDH, BSPH, examines the evolution of the human skull.
Give it a watch, and make...
A Hygienists’ Review of Obtaining Medical Clearance before Dental Treatment
During my clinical career in dental hygiene, I had the opportunity to work in five different dental practices across three states. Some were private...
Curiosity Killed the Plaque Ep. 34: Diagnostic Errors in Dentistry
In this episode of Curiosity Killed the Plaque, Spring Hatfield, RDH, BSPH, takes a look at diagnostic errors in dentistry.
Give it a watch, and...
Curiosity Killed the Plaque Ep. 33: Medical Clearance for Dental Care
In this episode of Curiosity Killed the Plaque, Spring Hatfield, RDH, BSPH, takes a look at medical clearance for dental care.
Give it a watch,...
Researchers Investigate Patient Perception of Dental Diagnostic Errors and Strategies to Reduce Occurrences
Diagnostic errors are a serious concern in health care settings. Though many people may only think of diagnostic errors from a medical viewpoint, dentistry...
Mendelian Randomization Analyses Look for Causal Relationships between Oral Health and Cognitive Decline
It's estimated that around 4% of American adults over age 65 have been diagnosed with dementia.1 Studies in the past have indicated that poor...
Curiosity Killed the Plaque Ep. 32: Central Sensitivity Syndrome
In this episode of Curiosity Killed the Plaque, Spring Hatfield, RDH, BSPH, takes a look at central sensitivity syndrome.
Give it a watch, and make...
Shining a Light on Microbial ‘Dark Matter’ of the Oral Microbiome
The oral microbiome is becoming more central in the understanding of oral health and disease. During the past decade, oral microbiology has progressed from...
Curiosity Killed the Plaque Ep. 31: Tuberculosis Refresher for Dental Hygienists
In this episode of Curiosity Killed the Plaque, Spring Hatfield, RDH, BSPH, takes a look at tuberculosis and gives a refresher for dental hygienists...
A Hygienist’s Overview of the Effects of Iron-Deficient Anemia on Oral Health
The human body is a scientific masterpiece with multiple biological functions. However, proper function and maintenance are required to keep it working like a...
Curiosity Killed the Plaque Ep. 30: HIPAA Compliance with Patient Records Requests
In this episode of Curiosity Killed the Plaque, Spring Hatfield, RDH, BSPH, takes a look at HIPAA compliance with patient records requests.
Give it a...
A Dental Hygienist’s Review of Tuberculosis in Light of the Kansas Outbreak
Historically, the United States has a low rate of tuberculosis (TB). However, there has been an outbreak of TB cases in Kansas. The outbreak...
Curiosity Killed the Plaque Ep. 29: Fluoride, IQ, and the Recent Court Ruling
In this episode of Curiosity Killed the Plaque, Spring Hatfield, RDH, BSPH, takes an evidence-based approach to discussing the recent reports on fluoride and...
Robust Evidence or Misinformation: 8 Tips for Vetting a Source
When I was younger, I would go to the library, find an encyclopedia, and look up the answer if I had a question about...
Critical Thinking: How Dental Professionals Can Reboot Thought Patterns
Carl Sagan once said, "The truth may be puzzling. It may take some work to grapple with. It may be counterintuitive. It may contradict...